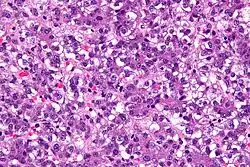

ورم أرومي كبدي
ورم أرومي كبدي (بالإنجليزية: Hepatoblastoma) هو سرطان خبيث غير شائع يصيب الأطفال والرضّع، يتكون نسيجيًا من خلايا مشابهة للخلايا الكبدية الجنينية والناضجة وخلايا القناة الصفراوية، يتظاهرعادًة على شكل كتلة في البطن، وغالبًا ما يُشخص خلال السنوات الثلاث الأولى من عمر الطفل.[1] يترافق الورم بارتفاع مستويات إلفا فيتو بروتين، ويسوء الإنذار في حال عدم ارتفاع مستوياته عند التشخيص.[2]
| ورم أرومي كبدي | |
|---|---|
![]() صورة مجهرية لورم أرومي كبدي بصبغة الهيماتوكسيلين والأيوزين. صورة مجهرية لورم أرومي كبدي بصبغة الهيماتوكسيلين والأيوزين. | |
| معلومات عامة | |
| الاختصاص | علم الأورام |
| من أنواع | سرطان الكبد |
| الإدارة | |
| أدوية | |
الأعراض والعلامات
غالبًا ما يكون المرضى غير عرضيين[3] عند تشخيص المرض، ولذلك فهو يكشف بمراحل متقدمة.
الفيزيولوجيا المرضية
ينشأ الورم الأرومي الكبدي على حساب طلائع الخلايا الكبدية غير الناضجة، ويكون وحيد البؤرة بشكله النموذجي، يصيب الفص الأيمن للكبد أكثر من الفص الأيسر، ويمكن أن يعطي نقائل. يُصنف هذا الورم إلى نوعين: النمط الظهاري، والنمط المختلط (الظهاري والمتعلق باللُحمة المتوسطة).
يتطور الورم الأرومي الكبدي لدى الأفراد المصابون بداء البوليبات الغدية العائلي، ويعرف هذا الداء على أنه متلازمة تجمع بين البوليبات القولونية التي تحدث بعمر مبكر، والسرطان الغدي.[4][5] أثبت أيضًا وجود طفرات بيتا كاتينين لدى المصابين بأورام الأرومة الكبدية المعزولة، وذلك عند ما يقارب 67٪ من المرضى.[6][7]
تبين وجود دور محتمل لمكونات مسارات التأشير«دبليو أن تي» الإضافية، في التسبب بإحداث الورم الأرومي الكبدي.[7][8] تتزايد الأدلة التي تثبت أن الورم الأرومي الكبدي مشتق من خلية جذعية متعددة القدرات.[9]
تتضمن المتلازمات المترافقة بخطر مرتفع للإصابة بالورم الأرومي الكبدي: متلازمة بيك ويزدمان، وتثلث الصبغي 18، وتثلث الصبغي 21، ومتلازمة أي كاردي، ومتلازمة لي- فراوميني، ومتلازمة غولدينهار، ومرض فون جيرك، وداء البوليبات الغدي العائلي[10]
التشخيص
يعتبر عيار إلفا فيتو بروتين الجنيني في الدم الطريقة الأكثر شيوعًا لتحري الورم الأرومي الكبدي. يستخدم مستوى إلفا فيتوبروتين كمؤشر حيوي للمساعدة في تحري وجود سرطان الكبد لدى الأطفال. تكون مستويات إلفا فيتو بروتين مرتفعة نسبيًا لدى الرضع، وتنخفض إلى مستوياتها الطبيعية عند البالغين بحلول السنة الثانية من العمر. يُعتبر المستوى الطبيعي لإلفا فيتو بروتين المصل عند الأطفال أقل من 50 نانوغرام لكل مليلتر (نانوغرام / مل)، و 10 نانوغرام/مل عند البالغين. يعتبر مستوى إلفا فيتو بروتين الذي يزيد عن 500 نانوغرام/مل مؤشرًا مهمًا على الإصابة بالورم الأرومي الكبدي. يستخدم عيارإلفا فيتو بروتين أيضًا كمؤشر على نجاح العلاج، إذ يعود إلى مستوياته الطبيعية في حال نجاح العلاج.[11]
المعالجة
استُخدِم لعلاج هذا الورم كلًا من الاستئصال الجراحي للورم، والعلاج الكيميائي المساعد قبل الجراحة، وزراعة الكبد.[12][13] توفر زراعة الكبد الأولية معدل بقيا مرتفع وطويل الأمد وخالٍ من الأمراض بنسبة 80٪، بينما يصل معدل البقيا في حالات الإزالة الكاملة للورم والعلاج الكيميائي المساعد إلى 100٪.[14][15] يعد وجود النقائل أقوى مؤشر على سوء الإنذار.[16]
علم الأوبئة
تمثل أورام الكبد 0.5-2% في المائة من أورام الأطفال وهي عاشر الأورام الأكثر شيوعا في الأطفال. احتمال حدوث الإصابة بورم أرومي كبدي هي 0.9 لكل مليون طفل. متوسط عمر التشخيص هو سنة واحدة؛ ويتم تشخيص معظم المرضى بعمر سنتين.[17]
مراجع
- http://hepatoblastoma.mditv.com/generalinfo%5Bاستشهاد+منقوص+البيانات%5D
- "Hepatoblastoma with a low serum alpha-fetoprotein level at diagnosis: The SIOPEL group experience". Eur J Cancer. 44 (4): 545–50. 2007. doi:10.1016/j.ejca.2007.11.022. PMID 18166449. الوسيط
|CitationClass=تم تجاهله (مساعدة) - Willert, Jennifer. "Pediatric Hepatoblastoma Clinical Presentation: History, Physical, Causes". emedicine.medscape.com. مؤرشف من الأصل في 31 مايو 2019. الوسيط
|CitationClass=تم تجاهله (مساعدة) - "The spectrum of APC mutations in children with hepatoblastoma from familial adenomatous polyposis kindreds". J. Pediatr. 147 (2): 263–6. August 2005. doi:10.1016/j.jpeds.2005.04.019. PMID 16126064. الوسيط
|CitationClass=تم تجاهله (مساعدة) - "Familial adenomatous polyposis in two brothers with hepatoblastoma: implications for diagnosis and screening". Pediatr Blood Cancer. 47 (6): 851–4. November 2006. doi:10.1002/pbc.20556. PMID 16106429. الوسيط
|CitationClass=تم تجاهله (مساعدة) - "Beta-catenin mutations and protein accumulation in all hepatoblastomas examined from B6C3F1 mice treated with anthraquinone or oxazepam". Cancer Res. 60 (11): 2864–8. June 2000. PMID 10850429. مؤرشف من الأصل في 7 أكتوبر 2018. الوسيط
|CitationClass=تم تجاهله (مساعدة) - Tan, Xinping; Apte, Udayan; Micsenyi, Amanda; Kotsagrelos, Emorphia; Luo, Jian-Hua; Ranganathan, Sarangarajan; Monga, Dulabh K.; Bell, Aaron; Michalopoulos, George K.; Monga, Satdarshan P.S. (2005). "Epidermal Growth Factor Receptor: A Novel Target of the Wnt/β-Catenin Pathway in Liver". Gastroenterology. 129 (1): 285–302. doi:10.1053/j.gastro.2005.04.013. PMC 1821080. PMID 16012954. الوسيط
|CitationClass=تم تجاهله (مساعدة) - "Elevated expression of Wnt antagonists is a common event in hepatoblastomas". Clin. Cancer Res. 11 (12): 4295–304. June 2005. doi:10.1158/1078-0432.CCR-04-1162. PMID 15958610. مؤرشف من الأصل في 7 أكتوبر 2018. الوسيط
|CitationClass=تم تجاهله (مساعدة) - "Stem-like cells in hepatoblastoma". Med. Pediatr. Oncol. 39 (5): 504–7. November 2002. doi:10.1002/mpo.10175. PMID 12228907. الوسيط
|CitationClass=تم تجاهله (مساعدة) - Zimmerman A, Saxena R. Hepatoblastoma. In: WHO Classification of Tumours of the Digestive System, 4th, Bosman FT, Carneiro F, Hruban RH, Theise ND (Eds), IARC, Lyon 2010. p.229.
- Sarto, I.; Klausberger, T.; Ehya, N.; Mayer, B.; Fuchs, K.; Sieghart, W. (2002). "A novel site on gamma 3 subunits important for assembly of GABA(A) receptors". The Journal of Biological Chemistry. 277 (34): 30656–64. doi:10.1074/jbc.M203597200. PMID 12065588. الوسيط
|CitationClass=تم تجاهله (مساعدة) - "Treatment outcomes for hepatoblastoma: an institution's experience over two decades". Pediatr. Surg. Int. 23 (2): 103–9. February 2007. doi:10.1007/s00383-006-1834-1. PMID 17119981. S2CID 11332782. الوسيط
|CitationClass=تم تجاهله (مساعدة) - "Liver transplantation for hepatoblastoma: results from the International Society of Pediatric Oncology (SIOP) study SIOPEL-1 and review of the world experience". Pediatr Blood Cancer. 42 (1): 74–83. January 2004. doi:10.1002/pbc.10376. PMID 14752798. الوسيط
|CitationClass=تم تجاهله (مساعدة) - Pediatric Hepatoblastoma في موقع إي ميديسين
- "Liver transplantation for hepatoblastoma: indications and contraindications in the modern era". Pediatr Transplant. 9 (5): 557–65. October 2005. doi:10.1111/j.1399-3046.2005.00354.x. PMID 16176410. الوسيط
|CitationClass=تم تجاهله (مساعدة) - "Hepatocellular carcinoma in children: results of the first prospective study of the International Society of Pediatric Oncology group". J. Clin. Oncol. 20 (12): 2798–804. June 2002. doi:10.1200/JCO.2002.06.102. PMID 12065556. مؤرشف من الأصل في 15 أبريل 2013. الوسيط
|CitationClass=تم تجاهله (مساعدة) - Hepatoblastoma - St. Jude Children’s Research Hospital نسخة محفوظة 02 مايو 2015 على موقع واي باك مشين.
روابط خارجية
- بوابة طب
- بوابة علم الأحياء الخلوي والجزيئي